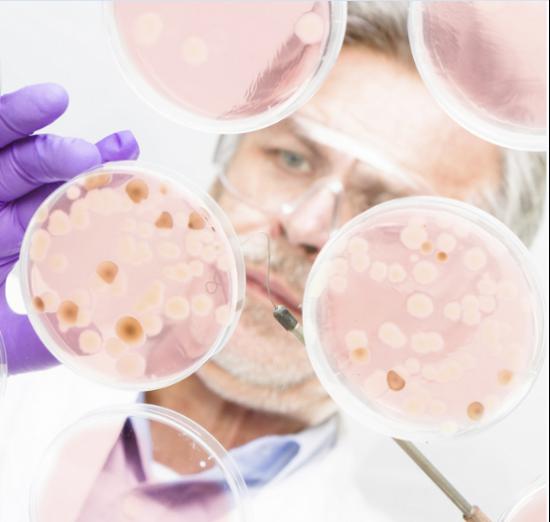

眼下,隨著24節(jié)氣中“大寒”的臨近,天氣越發(fā)變得寒冷,面對整個冬季最嚴寒的時節(jié),人們對熱水器的依賴和需求在不斷加大。此時,下班回家后如果能舒舒服服地洗上一個熱水澡,想必也是一大享受。可是,您知道我們每天洗澡用的水存在很多健康隱患嗎?近日,在網(wǎng)絡(luò)上流傳著這樣的一條新聞:電熱水器儲水箱已成為細菌繁殖的“溫床”,存在著大量的細菌。聞聽此消息后,不少市民對自家的電熱水器深表擔憂。

熱水器儲水箱成“細菌溫床”
網(wǎng)上所說的一切是真的嗎?行業(yè)專家就此問題這樣回答記者:我們?nèi)粘T诩依锸褂脙λ愲姛崴飨丛钑r,并不能一次性地把儲水箱里面的水全部用掉,水箱中大概有20%-30%是靜態(tài)的剩水。再加上電熱水器的儲水箱又長期處于40℃~60℃,這個溫度是最適宜細菌的大量繁殖。如果電熱水器的儲水箱存水幾天不用,細菌便會成幾何倍數(shù)增長,滋生大量如大腸桿菌、沙門氏菌等細菌和亞硝酸鹽。
另據(jù)記者了解,當我們進入沐浴室后,熱水一開,就會產(chǎn)生騰騰蒸氣,而人體的毛孔遇熱會擴張,如果熱水中含有大量大腸桿菌、沙門氏菌等細菌,就會通過張開的毛孔進入到我們的身體中,造成皮膚損害,產(chǎn)生頭屑、痘痘、濕疹等皮膚病。尤其是抵抗能力較弱的寶寶,新陳代謝較為緩慢的老人,最易受到細菌威脅。
銀網(wǎng)抑菌技術(shù),拒絕“細菌”襲擾
那么在洗澡時,怎樣才能有效避免“細菌”襲擾我們的身體健康呢?記者咨詢了全球領(lǐng)先供暖熱水專家阿里斯頓。據(jù)介紹,為了解決熱水器儲水箱中細菌滋生這一頑疾,阿里斯頓以自然界中最安全、抑菌率最高、抗有害菌種類最多的銀離子技術(shù)為創(chuàng)新突破口,成功研發(fā)出創(chuàng)新AG+銀離子抑菌技術(shù),徹底解決了儲水箱細菌滋生的難題,讓用戶洗澡時再無“細菌”襲擾,享受到健康舒適的沐浴新體驗。

實驗證明,銀離子的殺菌效果是一般殺菌劑的一百倍以上,且殺菌范圍非常廣泛,可有效殺死超過600種病原菌,而且不會產(chǎn)生其他有害物質(zhì),更不會形成二次污染。阿里斯頓就是利用銀離子超強的物理抑菌能力,全面抑制細菌的繁殖,防止細胞代謝,干擾細菌微生物體DNA的合成,使之喪失分裂繁殖能力而死亡,從而起到保持水質(zhì)健康潔凈的作用。
行業(yè)觀察人士指出,電熱水器儲水箱水質(zhì)問題日益受到用戶重視。阿里斯頓AG+銀網(wǎng)抑菌電熱水器從用水健康方面深挖用戶痛點,通過研發(fā)創(chuàng)新技術(shù),解決了圍繞在消費者身邊的“細菌”問題,給消費者帶去了真正的“健康水”,開啟健康沐浴新時代。